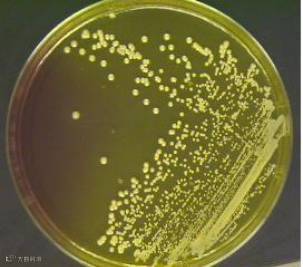
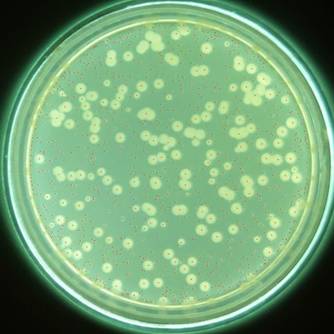
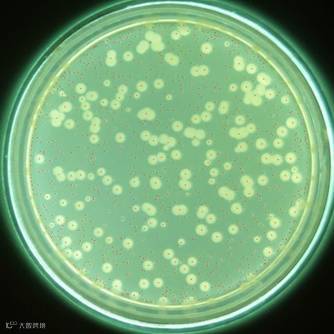

一块肉,你要是不经过处理放一个星期,它就会变得黑不溜秋的,上面还长“毛”,我们黑话就说这个肉腐烂了。这个变烂的过程称为“腐”。“腐”只是表象,本质是微生物的增长。
在化妆品中“腐”是指☞化妆品变质,更准确的说是化妆品遭到微生物的污染。其原因是我们四周都存在着大量的各种各样的微生物(包括细菌、病毒、真菌和少数藻类等)。
而我们做出来的化妆品,大多是由有机组分(如油脂、水溶性高聚物、各种营养成分等)组成,不仅有丰富的碳源、氮源等营养成分可供微生物生长繁殖所需,而且化合物的氧化作用也可为其的繁殖提供化学能,这种环境对于微生物来说,这就是传教士向往的天堂,道士迷恋的大罗天、唐僧惦记的西方极乐呀!怎么能够辜负如此美意,微生物那是大吃大喝,拼命繁殖下一代,努力为种族做贡献。
“防腐”顾名思义,就是防止腐败。一般来说两个方面:断其根源,比如上段那块肉,你要是全吃光了,微生物也没有繁殖来源,所以化妆品这东西,虽然有个保质期(通常是3年),但是因为很多环境因素的影响导致不一定能够坚持到那个时候,所以能早点用完比晚点用完要好;还有就是“废了你”,就是我们化妆品中使用防腐剂,废了微生物,阻止微生物生长,以保证产品质量安全。

又要放出来这个图了,这是《化妆品安全技术规范》(2015版)中对化妆品中微生物的要求。化妆品领域的微生物只是生物学领域微生物中的一部分。主要是细菌、真菌和霉菌为主(病毒呀,藻类呀等等我们统统不管)。上面检查的是各种微生物是比较有代表性却不仅仅是这几类微生物。
大肠杆菌
放大七万倍下的大肠杆菌
我们通常将大肠埃希氏菌(Escherichia coli)称为大肠杆菌。
1885年,Escherich发现了大肠杆菌。在很长的一段时间内,人类始终将大胺杆菌当作正常肠道菌群中的一部分,并认为它是非致病菌的。
一直到了20世纪中叶,才发现到某些大肠杆菌的致病性。
大肠杆菌主要寄生在大肠内,是数量最多且最为主要的一种细菌。人在感染大肠杆菌后,主要症状为呕吐、腹泻、发热、胃痛和胃出血,而对于老人和孩子,有高度传染性,严重者可致死。
大肠杆菌是呈革兰氏阴性反应,属于需氧及兼性巧氧的菌群,并且生化活动能力较强。如果在化妆品中检验出含有大肠杆菌,可能在接触或使用后通过一定的途径进入人体,引起肠道性疾病,使用感染粪大肠菌群的化妆品会对消费者存在潜在的危险。
金黄色葡萄球菌
金黄色葡萄球菌(Staphylococcus aureus )是人类的一种有害的病原菌,隶属于葡萄球菌属,有“嗜肉菌”的别称,是革兰氏阳性菌的代表,为需氧或兼性厌氧类细菌。
金黄色葡萄球菌在自然界中无处不在,空气、水、灰尘及人和动物的排泄物中都可找到,其耐热耐干耐紫外线,对身体危害极大,是经常导致局部化肢感染甚至全身感染的病原菌,所以金黄色葡萄球菌又称为化脓性球菌。
美国疾病控制中心报告,由金黄色葡萄球菌引起的感染占第二位,仅次于大肠杆菌。
铜绿假单胞菌
铜绿假单胞菌(P.Aeruginosa)原称绿脓杆菌,是土壤中最常见的细菌之一。
该菌广泛分布于自然界中(如水、空气、肠道、呼吸道和皮肤等),喜潮又耐干,对紫外线不敏感,湿热55℃后才被杀灭。
它属假单胞菌属,是一种革兰氏阴性杆菌。铜绿假单胞菌对人类有致病,烧伤、烫伤及外伤患者感染上铜绿假单胞菌常常会使病情恶化,严重时可引发败血病;眼睛受伤感染后可使角膜溃瘍并穿孔,严重时可导致失明。经常引起术后伤口感染,也可引起褥疮、脓肿、化脓性中耳炎等,烧伤后感染了铜绿色假单胞菌可造成死亡。
含水分较多的化妆品、原材料等容易受到铜绿假单胞菌的污染。其对化学试剂的耐药性比一般的革兰氏阴性菌强得多。
霉菌(molds)

霉菌是形成分枝菌丝的真菌的统称。霉菌有着极强的繁殖能力,而且繁殖方式也是多种多样的。
霉菌的繁殖能力一般都很强,而且包含了有性繁殖和无性繁殖。霉菌在自然环境中分布非常广,在人类的生活中随处可见。化妆品配方中含有多种营养成分如胶原蛋白、多化、氨基酸、天然来源的植物营养液等,再加上适宜的温度和酸碱环境,非常适合霉菌的生长繁殖。
据统计,化妆品微生物感染中最常见的就是霉菌污染,在面贴膜类产品中尤其明显,因此霉变是导致化妆品变质的一个重要因素。
霉菌毒素对人和畜禽主要毒性表现在神经和内分泌紊乱、免疫抑制、致癌致畸、肝肾损伤、繁殖障碍等。
酵母菌(microzyme)

酵母菌喜欢生活在偏酸性潮湿含糖的环境中,在缺氧环境中生存,在自然环境中随处可见。
其中,白色假丝酵母(或称白色念珠菌)(Candida albicans)是一种真菌,通常在人体的多个部位存在,如口腔、上呼吸道、肠道,当人体免疫力下降或者体内菌群失去平衡时,该菌就会大量生长和繁殖,引起炎症而发病。
化妆品生产制造过程中,若不注意自身卫生,将自身携带的白色念珠菌带入广品中,会引起广品的变质。
大家都知道防腐是不能不防的,没有防腐功能或者防腐功能不够的产品,质量上肯定不过关,而消费者使用遭受微生物侵害的产品,轻则致病,重则致死。
其实很多人还没有明白防腐和杀菌的区别(实在是那些电视广告里面老是一起说有防腐杀菌功能),其实还有一个灭菌和消毒。
有人要说潇哥搞这么多我是真的傻傻分不清楚呀。
其实,防腐、消毒、杀菌、灭菌是个层层加强的趋势。防腐是通过某些手段避免产品因微生物而腐败。
潇哥黑话就是,不弄死你但是不准你生长;杀菌狠一点,要弄死病原微生物达到不能致病的限度;杀菌要更猛一点,要弄死一切致病菌,但是芽孢、嗜热菌等非致病菌没有办法;灭菌是最厉害的,就像古代的屠城一样,要把内外部的一切微生物都弄死并永远丧失其生长繁殖能力。
化妆品中的防腐是通过添加化学防腐剂对微生物生长进行抑制。通常这个防腐剂需要作用到微生物一个到多个细胞内的靶点,对细胞造成伤害直至其死亡。因此越是针对性强、仅对单一微生物起作用的,我们反而考虑的越少。
能够作用到多种微生物,对微生物中多个靶点起作用才是我们考虑防腐剂选择的主要趋势。
作用的靶点通常是4个:
1、细胞壁
2、细胞膜
3、蛋白质
4、核酸及遗传物质
靶点:细胞壁

细胞壁这个大家不陌生,高中生物的送分知识点,主要用来区分原核生物和真核生物,因此细菌和真菌都有细胞壁。
多说一点,细菌的细胞壁主要成分是肽聚糖,而真菌细胞壁的主要成分是壳多糖。因此我们可以通过添加一些化学成分对细胞壁尤其是肽聚糖和壳多糖产生破坏、阻止其合成新的细胞壁、溶解已生成细胞壁、破坏其表面结构。细胞壁功能被破坏了的微生物会很快的就挂了。
比如说,一些抗菌药物就是影响了细菌的细胞壁合成,洗涤剂和醇类也能够干扰细胞壁,尤其弄死一些革兰氏阴性菌非常有效。
靶点:细胞膜

微生物细胞膜
几乎所有的生物细胞都是有细胞膜的(没有个膜包裹就会漏呀),细胞膜的主要成分是脂质和糖蛋白(多糖和蛋白质,因此糖蛋白是两个成分不是一个成分)。
高中还有一个送分知识点就是细胞膜是双向传输选择膜(不是你想进就让进、想出就能出的)。
如果细胞膜收到干扰或者破坏,那细胞就会丧失选择性渗透掌控能力,细胞内有用的成分就会猛的往外流,外界有害的成分就猛的往里面进。
这种情况对于细胞是致敏的,因此就能毒杀微生物细胞。
表面活性剂就是这样一种化学物质。它既含有亲水基团,又含有亲油基团,他能从物理上结合脂质层,渗透细胞膜内部的亲水区域。而它能作为一种杀菌剂,就是因为它能降低细胞膜的表面张力(尤其是阳离子表活)。
其实多元醇的防腐机理多多少少也是这样,通过溶剂效应在细胞膜上面敲一个缺口,让细胞内容物流出,致使细胞死亡。
那怎么破坏细胞膜的通透性呢?还是考虑怎么破坏脂质、多糖和蛋白质为主。
靶点:蛋白质

无论是微生物还是整个生物圈,大多生命体的形成及延续是需要蛋白质的功效。蛋白质是一种空间型功能大分子。
我们可以通过一些抗菌手段使蛋白质丧失起性能甚至使蛋白质死亡。简单点就是改变蛋白质的化学键或者改变其空间的三维结构,这时候我们称为蛋白质的变性。化学键的破坏会导致蛋白质结构的展开或者变成随机的、非常规的环或卷的结构。
蛋白质加热到一定温度能够永久失活,但是我们化妆品防腐用不上这个必杀技。但是我们能够试用一些比较强有机溶剂(醇,酸)进而造成蛋白质凝固。一些杀菌剂,比如金属离子,会和活性蛋白结合,阻止其相互作用产生正确的产物。这种阻止蛋白质的方法在防腐上的应用,意义非凡。

靶点:核酸
核酸是微生物繁殖和生存必不可少的物质。DNA必须在新生的细胞中规律的复制和转录。任何影响这个过程的东西都是潜在的抗菌手段。
某些成分结合在DNA上可以阻断其转录和传递,另一些则是诱变剂。伽马,超声,X射线造成诱变,导致DNA永久性失活。像甲醛和环氧乙烷之类的化学物质也会影响DNA和RNA的功能。

常用防腐剂
尼泊金酯这几年的前途不顺呀,因为皮肤刺激、扰乱内分泌和致癌性等因素而备受质疑。欧美很多儿童化妆品产品已经开始停止使用,并在产品标签上宣称“free of paraben"。
现在除了甲乙丙丁四个还能用,其余都不能用了,而且法规对尼泊金酯的用量那是一降再降。
当然在法规没有明确规定其不能用之前,还是十分有市场的。
尼泊金酯类防腐剂除了甲酯是水溶性,乙酯以上都是油溶性。因此在使用尼泊金酯的时候我们要考虑好它在体系中的水油分比以及其pH环境,通常pH越低尼泊金酯类的防腐效果会有所提高。
For example,尼泊金甲酯是适用于酸性体系的防腐剂,当pH5时,本身具有77%的最高抑菌活性,pH7时为63%,当pH8.5时接近50%。尼泊金酯正儿八经的名字应该是对羟基苯甲酸酯,由于它具有酚羟基结构,所以抗细菌性能比苯甲酸、山梨酸都强。
目前尼泊金酯还是防腐剂中使用的大类,法规不动的话,估计很多产品还是很坚持的。
咪唑烷基脲是一种化妆品中的防腐剂,具有广谱抗菌活性,能抑制革兰氏阴性、阳性细菌,对酵母菌及霉菌有一定的抑制作用,主要用于抑制微生物的繁殖,可与化妆品中存在的各种组分相配伍,试验结果表明其抑菌能力不受化妆品中表面活性剂、蛋白质以及其它特殊添加成分的影响。
其实用性很强,几乎能与化妆品中所有组份互配。适用于化妆品的pH值范围为4-9,可在较宽的温度范围内(<90℃)添加。可用于乳霜、香波、露液、调理剂等产品,可单独使用,也可与尼泊金酯类、IPBC等配合使用,增强其防腐效果。
例如市场上有GermallⅡ、GermabenⅡ-E、Germallplus、GermallIS-45等。
但是作为一个典型的甲醛释放体,潇哥对它的前途堪忧。尤其是有报道说今年7月欧盟法规建议把甲醛作为禁用成分。这意思就是甲醛在化妆品中是不得检出,作为喜欢跟着欧洲走的中国法规,估计不久尼泊金酯这类甲醛释放体要寿终正寝,驾鹤西去了。
全称是5-氯-2甲基-4异噻唑啉-3酮和2-甲基-4-异噻唑啉-3-酮(CIT/MIT),卡松最大的特点有两个:1、就是具有良好的配伍性,能够和非离子、阳离子、阴离子及各种离子型的乳化剂、蛋白质配伍;2、特别便宜。
也是甲醛的供体,去年到今年,欧盟法规对其使用限量更加严格了。
使用中,pH环境对卡松的影响很明显,在偏酸性的环境下用量很少就有很好的防腐功效。然而在碱性条件下,几乎没有防腐活性,因此最佳pH环境为4-8。并且可通过添加盐来增加其渗透压,从而使其防腐活性得到提高。
这类产品主要应用于膏霜、护发素、乳液、染发剂和洗发液等产品中,一般不用于眼睛用品、口红、牙膏等。在使用本产品的时候必须考虑原料之间的相容性问题,以免发生沉淀,特别是在透明产品中,要十分小心。
问题来了,2017年7月7号,欧盟把甲基异噻唑啉酮用量在淋洗类降到0.0015%。
2016年7月,欧盟委员会在颁布的(EU)2016/1198修订案中规定甲基异噻唑啉酮只能作为防腐剂在淋洗类化妆品中使用,允许的最大浓度为0.01 % w/w (100 ppm)。该法规在16年8月正式生效。同时自2017年2月12日起,只有符合该法规的化妆品才可在欧盟市场上销售。
在时隔不到一年时间后,欧盟委员会再次降低甲基异噻唑啉酮的使用限量,于上周颁布(EU) 2017/1224号修订案,将淋洗类化妆品中甲基异噻唑啉酮的最大浓度从0.01 %下调至0.0015 %。
潇哥在想,下次再修订的时候是不是就是我们和甲基异噻唑啉酮或者卡松说bye-bye的时候了?
这种防腐剂简称IPBC,是一种较新型的防腐剂,并应用于化妆品中,属于氨基酸类衍生物。
根据美国FDA的化妆品防腐剂的使用目录中,IPBC开始有登记使用的是在1996年。
对比其它化妆品防腐剂,它在防霉、杀真菌方面具有较好的效果,并且配伍性佳,试验结果表明其抑菌能力不受化妆品中表面活性剂、蛋白质以及中草药等添加物的影响。可和化妆品中的各组分或其它防腐剂相配伍。
欧盟对此成分在化妆品及个人护理品中的使用限量(清洗类0.02%,护肤类0.01%,除臭/止汗类 0.075%),并建议应避免用于口腔、唇部护理以及大面积使用的润肤露等产品,三岁以下的婴幼儿更应避免使用。与中国《化妆品安全技术规范》(2015年版)类似。
在医药上氯苯甘醚属抗真菌药物,适合用作抗真菌、细菌、阴道霉菌、毛滴虫病症等。在化妆品中,我们也常用氯苯甘醚来抗真菌,氯苯甘醚对黑曲霉、嗜松青霉有较强杀菌活性,对白色念珠菌和酿酒酵母也有很好的抑制作用。
《化妆品安全技术法规》(2015版)中规定,在化妆品中,氯苯甘醚的含量不大于0.3%,但对使用的范围没有明确限制,也就是氯苯甘醚可用于皮肤和毛发的产品,也可用于与眼睛和粘膜接触的产品。
也叫双咪唑烷基脲。它的外观主要为白色流动性粉末,基本无味或者微有特征气味。基本特征与咪性烧基服相似,可应用于较广的pH值范围内。其稳定性很好,配伍性较佳。
抗细菌活性较好,抗霉菌的活性较差些。CIR已经证实其使用浓度为0.5%时是安全。
咪唑烷基脲的升级版,甲醛释放体之一,前途堪忧!
季胺盐-15的化学名称是氯化3-氯烯丙基六亚甲基四胺,外观为类白色粉末。在一些易变色的配方中通常的作法可以添加少量的亚硫酸盐进行预防。
由于当前国际上对于季胺盐-15在化妆品中的使用规定没有达成一致,所针对于季胺盐-15因为释放甲醛而造成产品问题也有着不尽相同的认识,之前食药监局组织开展有关季胺盐-15的安全性评估与监测工作,评估这么久也没有什么信息出来,潇哥估计以后也就没有什么好评估了。
苯氧乙醇的杀菌机理是作用于细胞膜,提高细胞膜对钾离子的通透性,抑制细胞生长需要的酶活性(如苹果酸脱氢酶)。
苯氧乙醇对绿脓肝菌有特效的抑菌性,可用其2%的溶液或乳剂治疗绿脓杆菌感染的表面创伤,灼伤和脓疡。另外还对革兰氏阳性菌和阴性菌有抑菌作用。
不过,苯氧乙醇对真菌的抑菌效果不佳,因而很少会单独使用,通常会与其他防腐剂或防腐增效剂共同使用,增大抗菌谱,同时降低使用量。
比较典型的是与乙基己基甘油复配使用(9:1)。
布罗波尔的全称是2-溴-2-硝基-1,3-丙二醇,能够较广泛的抑制微生物繁殖,对于大部分的细菌能够有效的抑制,尤其是革兰氏阴性菌。
在碱性或高温环境中不太稳定,在太阳光照下会发生颜色变化。布罗波尔可和大部分表面活性剂相配伍,但是当化妆品配方中包含有基团-SH的原料时(如半脫氨酸等),会使其的抑菌活性降低。目前已经有很多报导指出其可能会使得亚硝胺的形成,从而有致癌的危险。
其实是很厉害的防腐剂,用量低的时候。用量高时具有广谱、高效的杀灭作用,比如革兰民阴性菌、酵母菌及病毒(如狂犬病毒、甲/乙肝、爱滋病毒)等,因此也能用在消毒类产品中。
高浓度用量时,其杀菌机理是通过直接破坏细胞膜,导致胞质中的核酸和蛋白质都发生不可逆变性,并且使得细胞内一些低分子量的溶物渗出,造成细菌死亡。
低浓度用量时,其抑菌机理是通过作用于细胞膜上,导致细菌在吸收对生长的必需氨基酸、尿嘧啶等营养物质方面受到阻碍,从而细菌的生长繁殖受到抑制,并且在极低浓度时(MIC)也能够达到这种效果。
但是,目前三氯生己被证实对环境有负面影响。去年九月,FDA就把它从皂中给禁了。也是前途堪忧的防腐剂,潇哥现在都是完全不敢用它了。
苯乙醇在自然界是普遍存在的,是一种具有幽雅迷人的玫瑰气味的芳香族伯醇。美国己被允许添加在食品中,在欧洲可被应用于人造香精,浓度约为2mg/kg。此外,有研究者对苯乙醇的刺激和过敏性进行测试,结果显示为阴性。
苯乙醇一直都被认为是抗菌活性物。1953年,科学家首次发现了苯乙醇可抑制革兰氏阴性菌生长,随后发现了苯乙醇不仅能够抑制这一类革兰氏阴性菌的生长,还对枯草芽抱杆菌、金黄色葡萄球菌等革兰氏阳性菌及部分分支杆菌同样具有抑制作用。
苯乙醇对真菌也具有抑制效果,抑制了酿酒酵母的呼吸,使得粗糙脉抱菌摄入氨基酸和葡萄糖时收到限制。
目前对于苯己醇的抗菌机理,尤其是在细菌方面的研究非常多。
具体总结为:
苯乙醇能够可逆性地抑制了DNA的合成,当DNA合成被抑制时会形成细长的丝状,而一旦培养基中不含苯乙醇时,细菌又会开始分裂增殖;
苯乙醇可通过对大分子物质的合成进行抑制从而使得细菌的生长受到抑制;苯乙醇能够抑制大肠杆菌蛋白和RDA合成;
苯乙醇通过作用于细胞质膜,抑制DNA的合成及其他功能结构的改变,并且能够引起细胞内钾离子大量泄漏,细胞膜渗透性増加。
前景十分好的防腐剂
由南京华狮化工有限公司提供的数据表明,月桂酰精氨酸乙酯盐酸盐对革兰氏阳性菌、革兰氏阴性菌、病原体、酵母和霉菌都具有很好都抑菌效果,且最低抑制浓度是8μg/mL,对致病性大肠杆菌、啤酒酵母、黑曲霉、李斯特菌的最低抑制浓度是32μg/mL,是一种安全、高效的防腐剂。
另外月桂酰精氨酸乙酯盐酸盐对李斯特菌(ATCC15313)的MIC是32ug/ml,李斯特菌的发病率大约为10万分之一,近年来多次在美国、欧洲、加拿大等地区引起重大疫情,越来越多的引起各个国家的重视,然而能够对李斯特菌具有有效抑制的抑菌剂缺少之又少,应用月桂酰精氨酸乙酯盐酸盐的巴氏杀菌法被证实对李斯特菌具有有效的抵抗性,可以将其应用在食品防腐剂中。
月桂酰精氨酸乙酯盐酸盐此前在欧盟允许作为化妆品防腐剂使用,除了唇部产品、口部产品和喷雾产品外,最大使用浓度为0.4%w/w。
2016年7月12日,为适应技术进步,欧盟发布(EU)2016/1121号委员会法规,修订化妆品法规((EC)No 1223/2009)的附件V,新增允许该物质作为防腐剂用于漱口水,使用浓度为0.15%w/w以下,但10岁以下儿童使用的产品除外。
前景good!
由山梨醇脱水与辛酸酯化的产物,具有一定的表面活性,通常用作乳化剂。
脱水山梨醇单辛酸酯于2010年前后由克莱恩公司以VelsanSC牌号作为多功能防腐增效剂推出。可通过增效作用提高防腐剂性能。
VelsanSC的效果可与苯甲醇和苯氧乙醇等活性剂相媲美,由于它的增效作用,配方中常规防腐剂或芳香醇的使用量可以得到降低。
VelsanSC已获得Ecocert(法国国际生态认证中心)认证。由于其未被列入防腐剂列表,因此可与其它未在列表中的活性物质配合使用,应用于各种宣称不含防腐剂的体系。
其最低抑菌浓度见下表:
最后总结一下:
1、防腐剂如何达到防腐功效的原理很重要,这是你选着防腐剂复配的依据。
2、甲醛释放体的防腐剂真多,大家这几年赶紧用,估计过不了多久就没机会了。
3、防腐的重要程度不仅仅是产品合不合格的问题,产品是死的人是活的,考虑人体健康才是考验一个行业的良心。
参考信息:
找原料《温和防腐剂——苯氧乙醇》
上海应用技术大学《The preparation and efficacy of a mixture preservation in cosmetics》
找原料《植物原防腐剂》
找原料《防腐原理和酚类防腐剂》
找原料《新型防腐剂月桂酰精氨酸乙酯盐酸盐》
找原料《氯苯甘醚》


